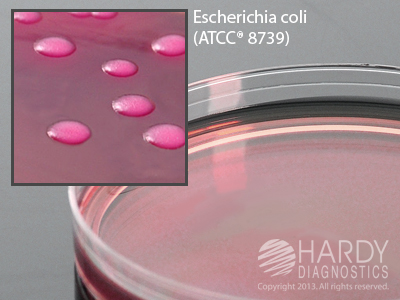
Violet Red Bile Agar w/Glucose

Medix Item Code: HVR-G178
Violet Red Bile Agar with Glucose, 15x100mm plate, by Hardy Diagnostics, For the detection of Enterobacteriaceae in foods. refrigerate on arrival.
Want to learn more about us? MedixCorp.com strives to put the customer first. Read here to find out how we can serve you!
Placing an order with Medix is easy! Shop on-line, or order by fax, e-mail, or telephone.
Need to get a hold of us? Medix offers many convenient ways to get in touch with our customer service team.
Want to save on many of our most popular items? Medix offers money saving new specials every month!
Common units include:
cs (case), pk (pack) and ea (each).